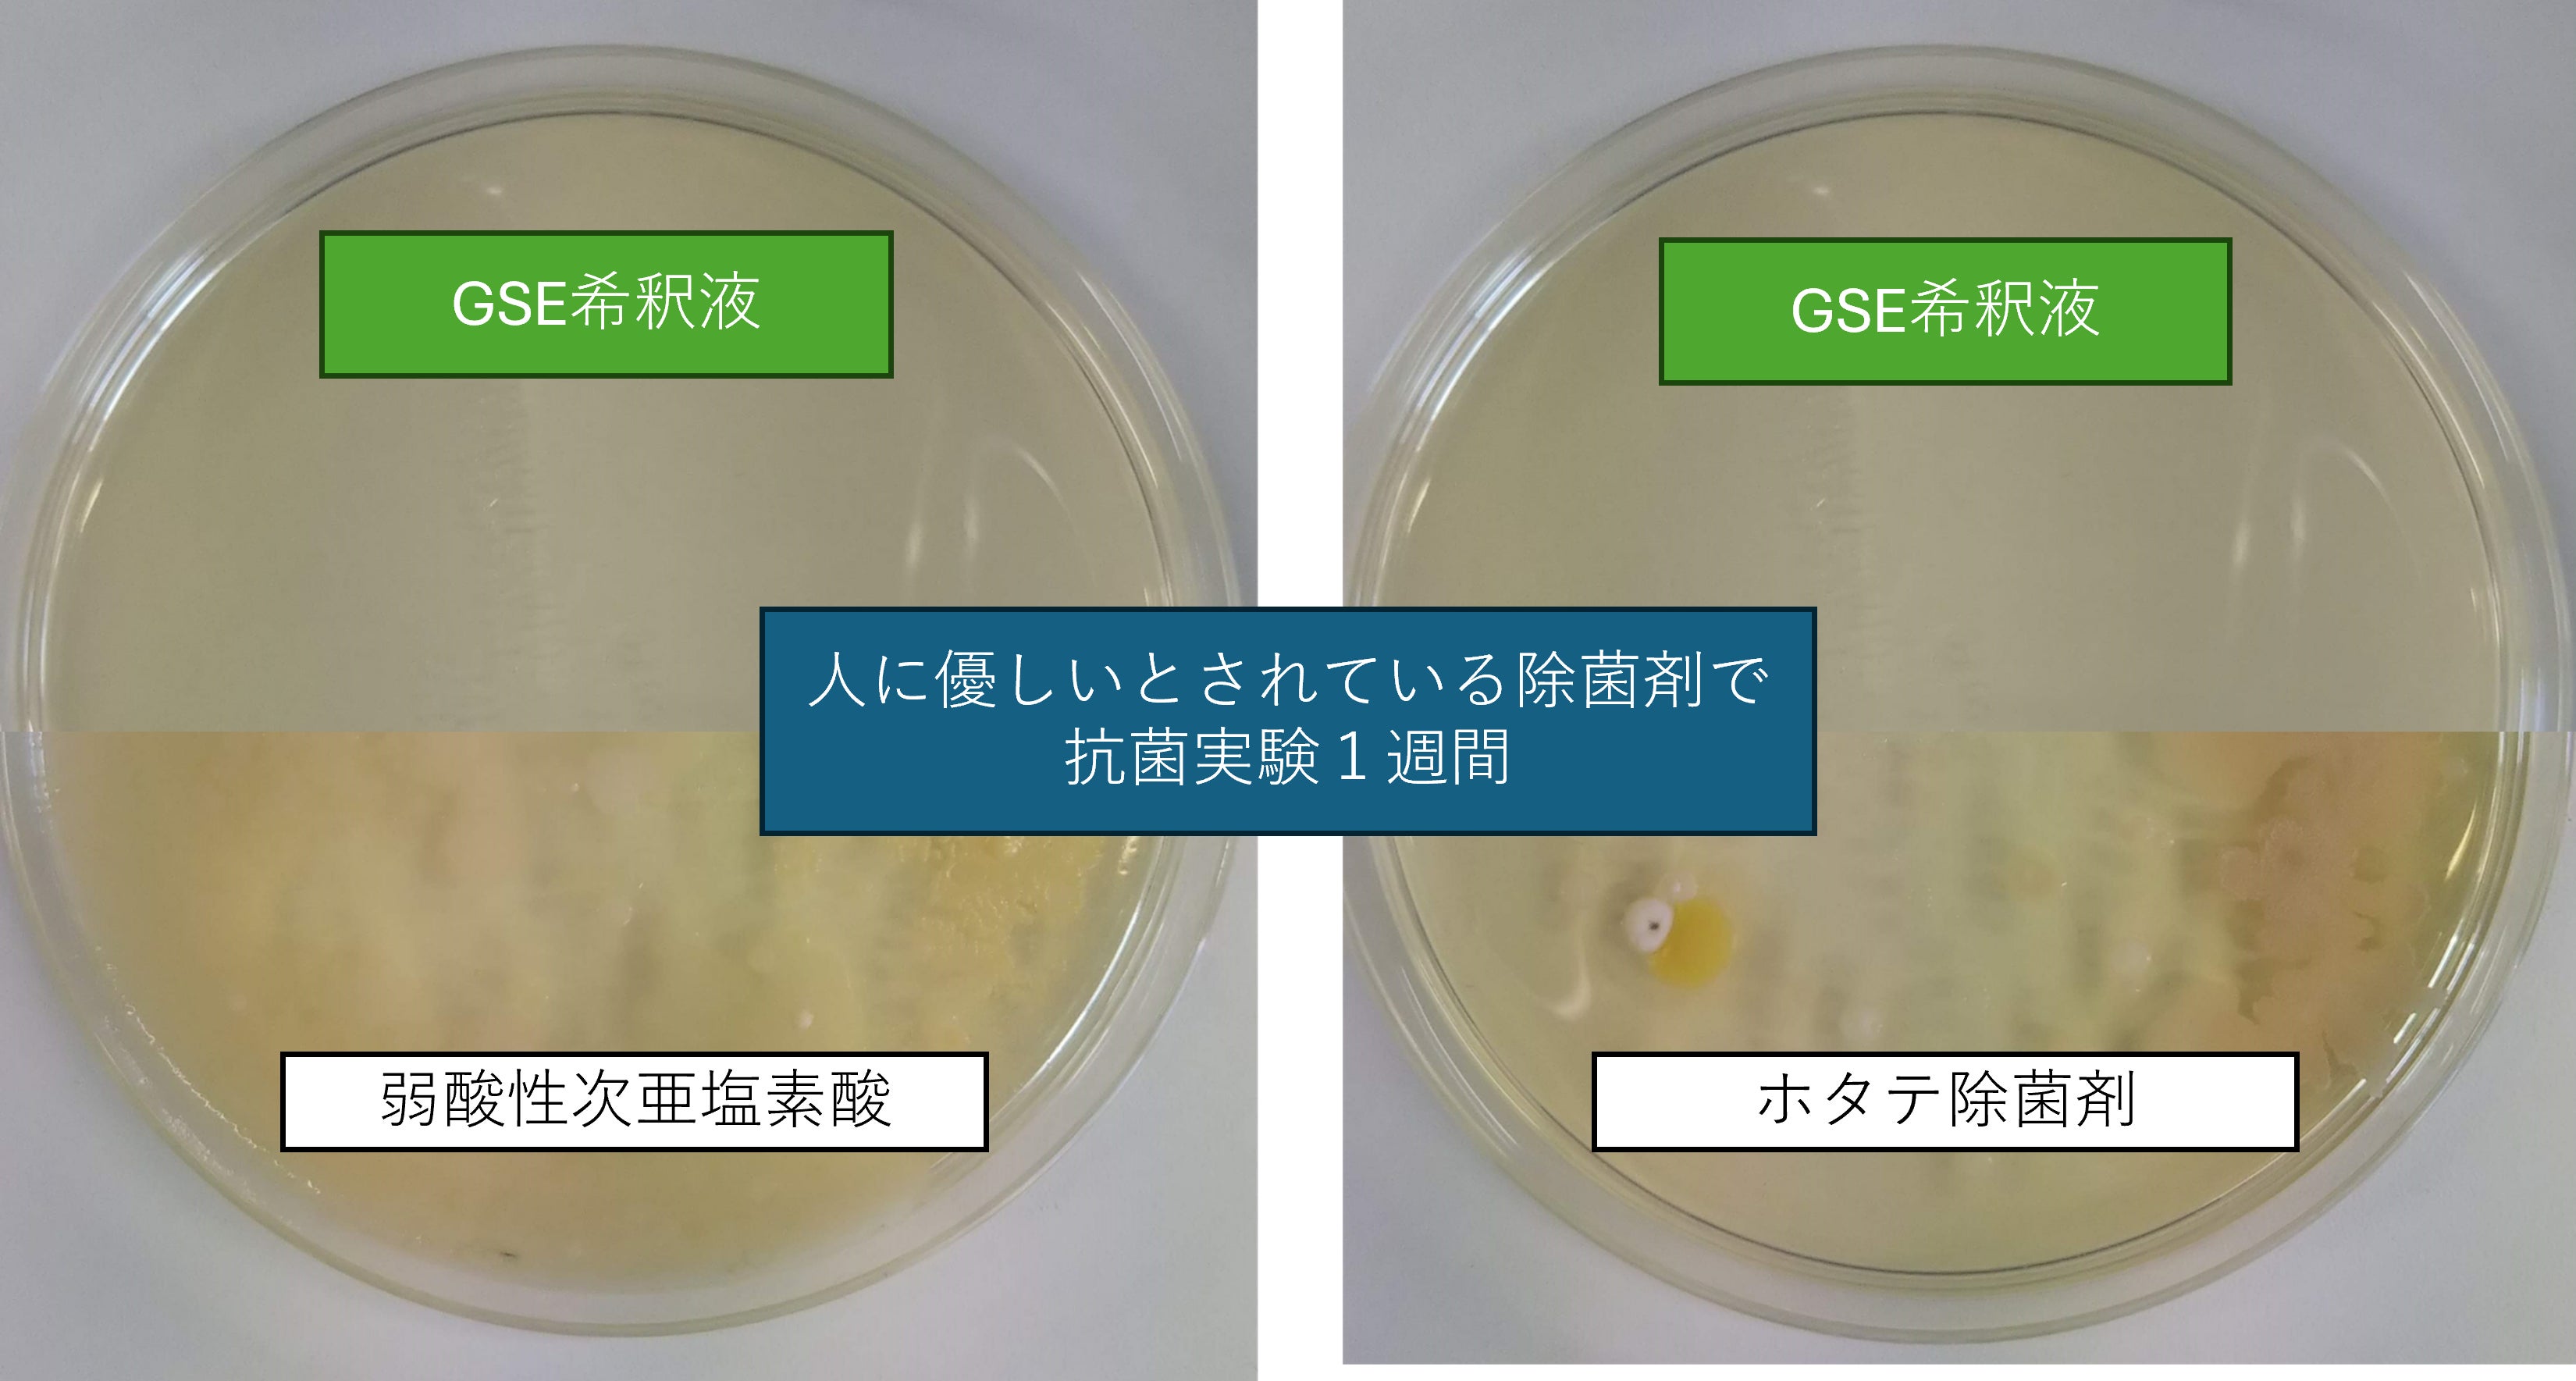
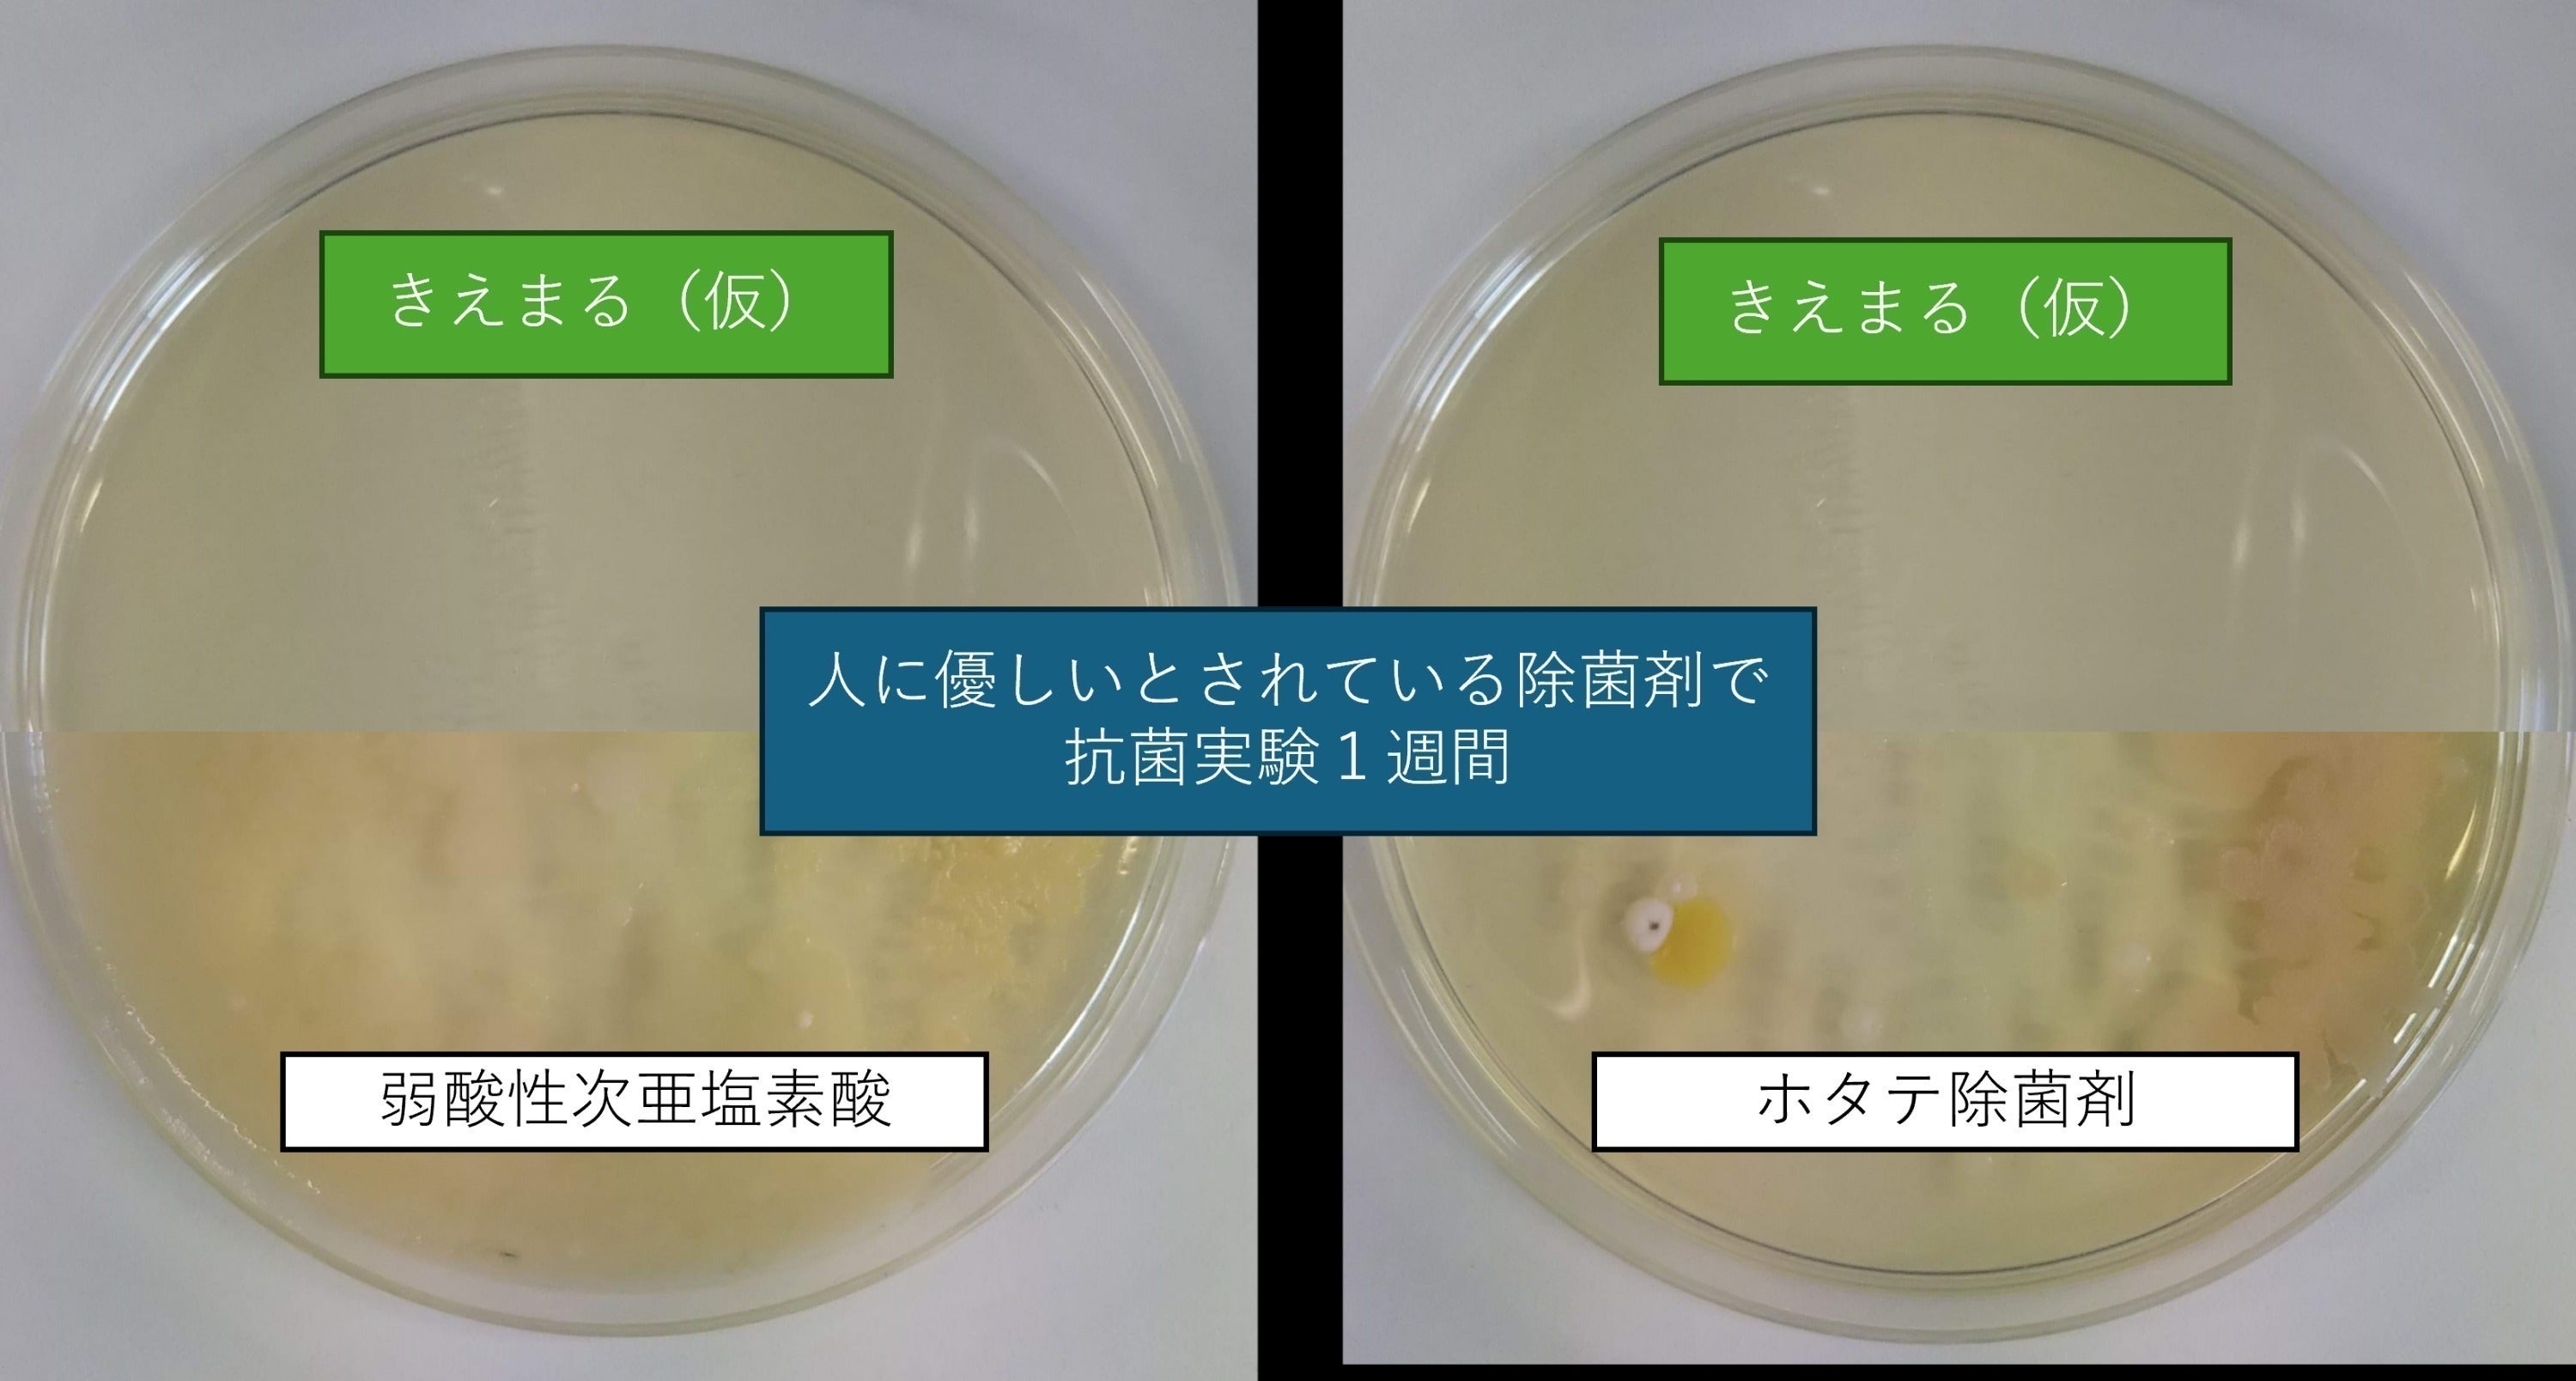

自己紹介
一般社団法人アルデバラン
一般社団法人アルデバランは、日本の医療とケアの質の向上を目指して活動しています。医療技術の進歩だけでなく、「心の豊かさを支えるケア」を大切にし、現場と学術、国内外をつなぐ架け橋として日々挑戦を続けています。
1,海外治療サポート
ドイツ・ミュンヘンのイサールクリニックにおけるオルト教授による再生医療をはじめ、最先端の細胞治療やがん治療の紹介と治療申込サポートを行っています。海外の高度医療に関する知見を日本へ還元し、希望のある医療のかたちを探求しています。
2,看護サービス
海外視察で得た知見をもとに、自費看護サービスや訪問看護ステーションを運営しています。また、発達障がい児支援にも取り組み、看護・介護の枠を越えた地域支援体制の構築を進めています。
3,施設コンサルティングと付随するサービス
有料老人ホームの運営支援や教育研修、職員育成などを通じて、高齢化社会におけるケアの質の向上に貢献しています。
一般社団法人アルデバラン代表理事 宮本芳恵
東京厚生年金看護専門学校(現・JCHO東京新宿メディカルセンター附属看護専門学校)卒業後、循環器内科・消化器外科・整形外科・泌尿器科・脳神経外科などで15年間の臨床経験を積みました。その後、介護老人保健施設や有料老人ホームで25年間、看護長・副施設長として高齢者ケア・終末期ケア・認知症ケア・臨床倫理・ACP(アドバンス・ケア・プランニング)教育に注力してきました。
2020年には産業能率大学情報マネジメント学部現代マネジメント学科を卒業(学士)し、医療と経営の両面から新しいケアモデルの構築に取り組んでいます。著書・論考も多数発表し、認知症ケアと意思決定支援の実践を広く発信しています。
2016年以降、フィンランド、スウェーデン、ドイツ、イタリア、スイス、オランダ、台湾など、世界各国の医療・福祉現場を継続的に視察し、高齢者ケア・認知症ケア・終末期ケアのあり方について深く学んできました。現地の専門家との情報交換を通じて、より良いケアの形を日本に生かす仕組みづくりを進めています。また、ドイツ・ミュンヘンのイサールクリニックでは再生医療に関する国際的な連携を推進。医療と福祉の両面から国内外の現場をつなぎ、「最期まで自分らしく生きる」ことを支える社会の実現を目指しています。
このプロジェクトで実現したいこと
GSEは、科学的根拠と自然の力が融合した「安心のかたち」です。抗菌・抗ウイルス・防カビ・消臭、そのすべてを、100%天然成分の液体で叶える革新的な存在。ただの「除菌スプレー」ではありません。
化学薬品や合成化学物質に頼らずに高い効果を発揮し、医療・介護の現場でも長年使われてきました。その安全性と有効性は、看護師としての臨床経験とデータが裏付けています。
一番の特長は「毎日安心して使える」こと。
ご家族の介護、子どもの健康習慣、季節ごとの感染症対策、生活空間の消臭や掃除など・・・
GSEは日常の“ちょっとした不安”を、やさしく支えてくれます。
――根拠ある安心を届けるために、このプロジェクトを実現したいと考えています。
プロジェクト立ち上げの背景
はじめまして。宮本芳恵と申します。

私は10年以上にわたり、高齢者施設で看護師として働き、「感染症」「清潔保持」「生活の質の向上」という課題に日々向き合ってきました。
医療や介護の現場は常に予期せぬトラブルと隣り合わせです。感染症が一人に広がるだけで、フロア全体、施設全体の安心が揺らぎます。だからこそ“清潔を保つこと”は、現場の私たちにとって最も重要な使命でした。
その日々の中で出会い、今では「なくてはならない存在」となったのが GSE(グレープフルーツ種子抽出物) です。
GSEは単なる消毒液や消臭剤ではなく、利用者様の暮らしと施設の環境を安心とともに守り続けてくれる信頼できるパートナーでした。私は看護師としてGSEと出会い、施設で大切な人たちの環境を守ることができました。
今度は、もっと多くのご家庭や日常の中で役立てていただきたい。誰もが心から安心できる暮らしを届けたい。
その想いから、このプロジェクトを立ち上げました。
科学と自然がつくる安心
GSEは、グレープフルーツの種子から抽出された天然成分です。
研究では、抗菌・抗ウイルス・防カビ作用が報告されており、細菌の細胞膜に作用して増殖を抑制し、真菌やバイオフィルム(菌の膜形成)にも効果を発揮することが知られています。
同時に、自然由来で肌や粘膜への刺激が少なく、日常的に使えるのが大きな特長です。強力な消毒剤は効果的であっても、日常使いには刺激が強すぎる。一方で「安心だけれど効果が弱い」製品では、現場では通用しません。
GSEは、“効果”と“やさしさ”の両立を実現した、非常に稀有な存在なのです。
現場で証明された確かな効果
私はこれまで、介護・医療の現場で数え切れないほどの場面でGSEを使ってきました。机上の理論ではなく、“現場で体感し、確信を得た”実例の一部をご紹介します。
●口腔ケアに
利用者様の口臭が驚くほど改善し、舌苔の予防にも効果的。
●排泄時の消臭に
排泄物の匂いが残らず、快適な空間を保てました。またバルンカテーテル特 有の臭気も軽減しました。
●感染症対策に
ノロウイルスを疑う汚物処理、自身や空間への噴霧。無害だからこそ安心して使え、感染拡大を防げました。
冬場は加湿器に入れて、施設全体の感染予防にも役立ちました。●創傷ケアに
刺激が少なく、洗浄と保護を両立。傷をやさしく守りながら清潔を保てました。
●生活環境の清潔保持に
テーブル、手すり、トイレ、リハビリ器具などに使用。
●衣類や布製品に
洗濯物を干す際にスプレーするだけで嫌な匂いが消え、食事用エプロンのケアにも最適。
●マスクに
外側の抗菌、内側の消臭で呼吸が快適に。利用者様にも職員にも好評でした。
●隔離室の感染管理に
感染症患者の退室後、GSEで処理し、安全にフロアを再開できました。
●手指消毒に
食事前やトイレ後、利用者様の手に直接スプレーできる安心感がありました。
これらはすべて、10年以上の現場で積み重ねてきた実感です。GSEは「幅広く、そして安全に使える」――その一点で、他に代えのきかない存在。私にとってGSEは、現場の安全を支える“静かな相棒”です。
実験しています!
GSEの論文や製薬会社で検証されていることが凄い‼
強力な抗菌性と選択性、無害であることと腸内フローラを害さないこと。選択性では敵である病原性細菌と、生理的細菌叢を構成する有益な細菌を区別することができる。
https://www.prodecopharma.com/en/products/brands/gs
海外では飲み物⁈
事実、海外では薬やサプリメントなど「飲む」「塗る」など幅広く使用されており、日本においては既存食品添加物(天然の食品添加物)として流通しています。
1.カンジダ治療薬として
2.抗生物質耐性菌を作らない
3.真菌感染症の治療
4.水虫と爪の真菌治療薬
5. 湿疹に伴う消化障害の治療
6. 一般抗菌剤としての働き
7.炎症を抑える
8.鳥インフルエンザウイルス(AIV),ニューカッスル病ウイルス(NDV),伝染性嚢病ウイルス(IBDV),サルモネラ・インファンティス(SI)および大腸菌(EC)に対する阻害活性
https://pubmed.ncbi.nlm.nih.gov/30713281/
9.GSEとキシリトールの点鼻液はin vitroでSARS-Cov-2に対して殺ウイルス活性を示す。
https://www.biorxiv.org/content/10.1101/2020.11.23.394114v1
など、多く広く研究され実績を残しています。
※基本、薬やサプリメントは海外でのことで、日本では作られていません。
GSEは800以上の細菌およびウイルス株、100以上の真菌株、および多数の単細胞または多細胞の寄生虫に対して有効であることが実証されています。
※弊社GSEはエビデンス取得済みです
このプロジェクトで目指すこと
皆さまのお力をお貸しください
私は看護師として、多くの方の生活に寄り添い、喜びや不安、希望や悩みを共にしてきました。その中で痛感したのは、「清潔を守ることは、生活の質を守ること」だということです。清潔で安心な環境があるからこそ、人は笑顔で日常を楽しむことができます。
このGSEは、医療や介護の現場だけでなく、家庭や子育ての場、そして日常のあらゆる場面で役立てることができます。大切な人を守りたいと願うすべての方に届けたい。そのために私はこのクラウドファンディングに挑戦します。
一緒に、安心できる毎日を広げていけたら幸いです。応援よろしくお願いします。
現在の準備状況
GSEを除菌抗菌消臭剤として使いやすい形で製品化するために、研究や開発、資材の選定など、毎日準備に奔走しております。
リターンについて
この度は、ご支援誠にありがとうございます。私たちは、GSE(グレープフルーツ種子抽出物)の素晴らしさをより多くの方に体感していただきたいと考えています。自然の力で健康をサポートするこの商品を通じて、皆さまの毎日がより豊かになることを願っています。
また、宮本芳恵が長年、病院や高齢者施設で看護師長として培ったノウハウと経験を皆さまと共有し、健康や介護に役立つ情報をお届けします。支援者の皆さまと想いを共有し、繋がりを深めることも大切にしています。
引き続き応援とご支援をどうぞよろしくお願い申し上げます。
スケジュール
2025年11月 クラウドファンディング開始
研究および資材などの選定
2026年1月 クラウドファンディング終了
2026年2月 WEB完成
2026年3月 リターン発送
最後に
このプロジェクトは、GSE(グレープフルーツ種子抽出物)の持つ科学的根拠と自然由来の安全性を活かし、新しい「安心」の形を皆さまに届けることを目的としています。抗菌・抗ウイルス・防カビ・消臭の効果を持つこの革新的な液体は、化学薬品や合成物質に頼らず、医療や介護の現場で長年実証されてきました。大切なのは、誰もが安心して日常に取り入れられることです。
私は、高齢者施設や医療現場での経験を通じて、GSEがもたらす静かな力とその効果を実感してきました。日々のケアや環境整備、感染症対策において、その安全性と有効性に確信を持っています。この経験を土台に、家庭や日常の中で誰もが安心できる暮らしを支えたいと願い、このクラウドファンディングを立ち上げました。
GSEは、実証された多様な効果と海外での広範な実績もあり、ただの除菌製品を超えた、自然と科学の融合による新しい安心の選択肢です。私たちは、この取り組みを通じて、家族や暮らしの中にもっと優しさと安全を広げていきたいと考えています。
皆さまのご支援と応援によって、より多くの人々が「根拠ある安心」を感じられる未来を共につくりあげていきましょう。どうぞよろしくお願いいたします。
★弊社使用のGSEはエビデンス・アレルギーテストなど人体に害がないことなど取得済みです。

コメント
もっと見る